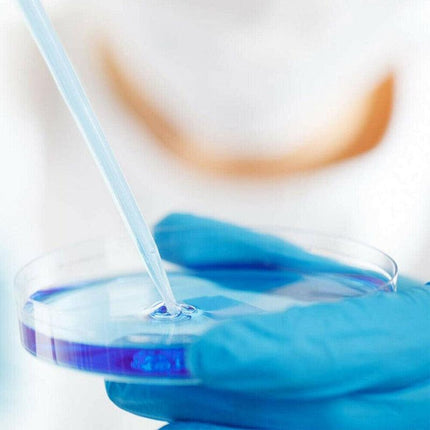

40pcs Essential Petri Dish Kit for Laboratory and Research Use
- AIMALL
$25.22
-
Guaranteed secure & safe checkout.
 Free Shipping over $29
Free Shipping over $29
Free Standard Shipping over $29 within Australia (excl. bulky items*).
Standard Shipping Within Australia- Flat Rate $6 below $29
Express shipping within Australia (excl. bulky items*) - Flat rate of $10 for orders below $29 and $13 for order over $29
Most products are shipped by Australia Post, Sendle, PFL Logistics, and Courier Please.
 Return & Exchange
Return & Exchange
For products you are not satisfied with, we have a 30-day return and exchange policy. This means you
have 30 days from receiving your item to request a return or exchange. Once we have received and examined your return, we will notify you and let you know whether to approve a refund or an exchange. lf you opt for a refund, you can then re-purchase the new product to make sure you get what you want. lf you choose an exchange, we will process it and send you the new product as soon as possible.
 Handling Time
Handling Time
Standard delivery usually takes 2-6 business days depending on your parcel destination (8
10 business days for western states and remote areas).
Depending on your parcel destination, express delivery usually takes 1 - 5 business days.
Please expect delays on holidays or during high-volume seasons.
Let customers speak for us
Frequently Asked Questions
When will my order be delivered?
Your order will be carefully packaged and delivered to your desired location. All orders will be processed within 1 to 2 business days after receiving the order confirmation email (excluding weekends and holidays). Once your order is shipped, you will receive another notification.
Can I return my product?
We have a 30 day return policy, which means you have 30 days after receiving your item to request a return. For all return requests, see our refund police.
What can I do if my item (or part of it) is damaged?
Please check your order upon receipt and contact us immediately if the item is defective, damaged or if you have received the wrong item. Please send a photo of the item together by email. We will resolve the issue as soon as possible.
You do not have to pay for return shipping.